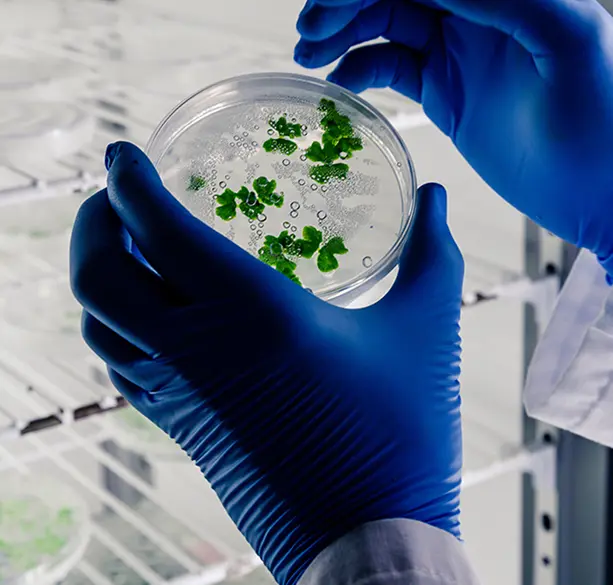

Why Biotech Brands Need Specialized
Content Marketing

In biotech, breakthroughs hinge not just on innovation but on conveying complex science in a way that resonates with audiences. Your audience could be investors, regulators, potential leads, or end-users. No matter who you’re targeting, your content needs to be easily understood.
Generic content will miss the mark entirely. You need deep domain knowledge combined with precision messaging to build credibility and trust.
A specialized content marketing approach tells the full story: from lab insights to real-world impact. It bridges the gap between technical complexity and audience understanding, enhancing visibility in scientific communities and regulatory bodies alike.
Select SEO strategies tailored to biotech terminology - like “gene therapy” or “biomanufacturing” - will ensure that your digital presence is elevated and poised to rise in a competitive landscape. In short, biotech brands require strategic, science-driven storytelling to position themselves as leaders in a high-stakes, rapidly evolving field.
How High-Quality Biotech Content
Boosts Growth
Quality biotech content writing services fuel momentum while providing valuable, insight-driven information. Thought-leadership articles, white papers, and case studies spotlight your breakthroughs and translate proprietary science into compelling narratives. This strengthens your standing with funding agencies and academic collaborators.
When paired with polished website copy and targeted SEO, your online ecosystem becomes an audience magnet, attracting qualified leads and overall media attention. Regular, well-crafted content also helps guide prospects along the sales journey, from early-stage education to deeper technical engagement.
At Goodman Lantern, we merge industry insight with editorial finesse to ensure that each piece reflects scientific rigor while driving credibility and commercial opportunity.
Work With a Specialized Biotech
Content Writing Agency
Partnering with a biotech content writing agency means you benefit from writers who speak your language. We don’t just draft marketing materials - we collaborate with your R&D and regulatory teams to translate complex data into clear, persuasive narratives.
Be it white papers, investor decks, case studies, or peer-reviewed content, our expertise spans the full biotech lifecycle. Our rigorous research and SEO-led workflow ensure your brand stands out in journals, online searches, and stakeholder engagement. Let us help your biotech story gain the attention - and respect - it deserves.

How Can We Help Your Biotech Brand Grow?

As a biotech content writing agency, we speak biotech fluently, without putting your audience to sleep. At Goodman Lantern, our team consists of experts who can turn even the most dense, technical jargon into sharp, story-driven content that actually gets read (and remembered).
Whether you're pioneering next-gen therapeutics or decoding genomes before breakfast, we help translate your brilliance into blogs, white papers, long-form articles, and web copy that converts. Think of us as your science-savvy storytellers - part content agency, part lab partner, all-in on your mission. We dive deep into your research, pull out the golden threads, and weave them into content that captivates investors and educates customers.
Our biotech content writing services are designed to help biotech brands show up smarter and more compelling than ever. Bottom line? You innovate. We communicate. And together, we help your biotech brand grow with purpose and personality.
Case Studies
Read all about our work for our clients in the case studies below.
We can help optimize website content for your online store
Our eCommerce content writing services were used by a well-known global manufacturer of power tools to optimize their product and category descriptions. Our involvement led to a 40% increase in website traffic.
Read more about our work hereUsing long form content, we can amplify yours sales and boost your online presence
An e-commerce software firm needed our services to create a long form content. This allowed us to offer consistent and compelling content to educate their audience.
Read their story hereHelping Hundreds of Businesses with
Our Expertise & Dedication


Our Clients Love Working with
Us Because We Make Your
Goals Our Own
At Goodman Lantern, we believe in building long-term, successful relationships with our clients. We take the time to get to know your business, as well as the people behind the brand. In the true spirit of collaboration, we do everything we can to tell your story and help your business grow.
Let’s TalkPricing Plans
We tailor-make packages and pricing structures to suit your budget. No matter what your content needs, we can work out a plan perfectly aligned with your requirements.
How Our Writers Enhance Your Biotech
Content Strategy
Biotech content isn’t just about facts but about framing innovation in a way that moves both markets and minds. Our biotech content writing services cover it all. We have a team of writers who are more than wordsmiths but domain-informed strategists and know that successful biotech messaging lives at the intersection of scientific precision and commercial relevance.
And, we don’t stop at translating complex research. We anticipate what your audience needs to know next and inform them before they become aware of it. Your audience could consist of an investor evaluating your IP pipeline or a healthcare professional skimming for clinical value. No matter who your target market is, we will tailor each piece to speak their language while staying true to yours.
Our writers collaborate closely with your regulatory, R&D, and commercial teams to align messaging with where your business is headed - be it FDA clearance, Series B funding, or market expansion. We track emerging biotech trends and factor in the nuanced expectations of regulatory bodies.
Every blog, white paper, case study, or landing page we create fits into a broader strategy. Every word is driven by data, every webpage and blog is built for scalability. Our team is positioned to learn and adapt your content as your science evolves. The result? Content that doesn't just inform, but drives credibility and measurable momentum for your biotech brand.
Biotech Content Writing FAQs
Biotech content requires subject matter fluency. Writers need to understand scientific terminology, regulatory nuance, and your target audience’s expectations. Without that expertise, content risks being vague, inaccurate, boring, or unconvincing.
Absolutely. Our writers are trained to distill dense, technical material into accessible language while preserving accuracy. We strike a balance to ensure that your science is understandable without compromising its sophistication or credibility.
Our biotech content writing services include creating white papers, investor decks, SEO-driven blog posts, and product explainers, to name but a few content formats. We also support peer-reviewed content, grant applications, and go-to-market collateral tailored for life sciences audiences.
Our writing team includes specialists with backgrounds in life sciences and technical writing. Every piece undergoes a research-intensive process and, when needed, internal peer review. We also work directly with your scientific and regulatory teams to ensure alignment.
Strategic content builds credibility and visibility, which are the two key drivers of growth. Whether you're preparing for a funding round or launching a product, content positions your brand as an expert and shows the world that your brand is ready for what’s next.

Get in Touch
Book a call with us today and find out how we can help grow your business. We will assist in planning a way forward, look at what your business needs are and develop a content plan accordingly.










